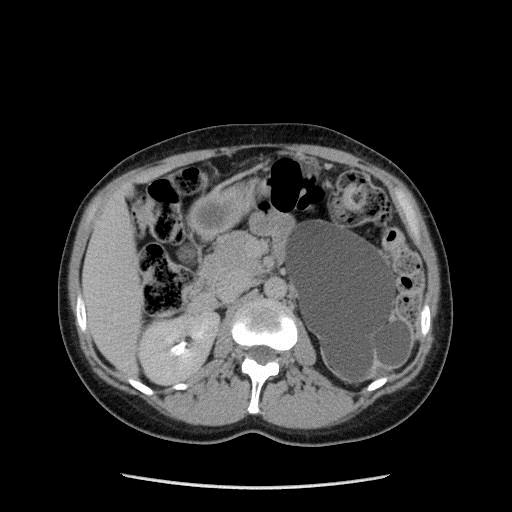

Pathologies du rein
LE SYNDROME DE JONCTION PYELO-URETERALE
Le syndrome de la jonction pyélo-urétérale est une malformation rénale pouvant être totalement asymptomatique pendant plusieurs années.
Il s’agit d’une dilatation rénale souvent due à une compression de la jonction pyélo-urétérale par une artère polaire inférieure. Dans certains cas, la dilatation n’est pas due à une compression mais à un défaut de péristaltisme urétéral à hauteur de la jonction pyélo-urétérale. Cette dilatation rénale chronique peut aussi entrainer des symptômes comme des douleurs évocatrices de colique néphrétique, des infections rénales, des calculs rénaux par stase urinaire et parfois une destruction du rein. Dans certains cas, le syndrome de jonction est découvert tardivement au stade de destruction du rein.
Un uroscanner et une scintigraphie rénale sont des examens nécessaires pour affirmer le diagnostic et évaluer la fonctionnalité du rein atteint.
En cas de souffrance rénale ou de symptomatologie chronique, il est nécessaire de corriger cette malformation en réalisant sous coelioscopie une plastie de la jonction pyélo-urétérale.
Photo : syndrome de la jonction pyélo-urétérale gauche avec importante dilatation rénale
KYSTES DU REIN
Les kystes rénaux sont des cavités remplies d’eau. Il s’agit d’une pathologie bénigne dans la très grande majorité des cas, très fréquente dans la population générale surtout après 50 ans. Les kystes simples ne nécessitent aucune surveillance alors que certains kystes dits atypiques justifient d’une surveillance radiologique annuelle.
Le scanner est l’examen de référence pour apprécier les caractéristiques d’un kyste. Certains critères radiologiques comme un rehaussement de paroi, des cloisons internes multiples ou des bourgeons charnus intra kystiques incitent à surveiller ces kystes en raison du risque de malignité. En cas de forte suspicion de tumeur kystique maligne, une exérèse chirurgicale est réalisée comme pour une tumeur du rein. En revanche, la biopsie pré-opératoire n’est pas recommandée en raison du risque de dissémination des cellules malignes par perforation du kyste.

Photo : kyste atypique suspect du rein droit
Les kystes simples sans aucun critère radiologique suspect ne nécessitent aucune surveillance ni aucun traitement sauf en cas de kyste symptomatique très volumineux responsable d’une gêne ou de douleur par compression des organes de voisinage (par exemple constipation par compression du colon). Dans ce cas les kystes peuvent être retirés sous coelioscopie.

Photo : kyste simple du rein droit